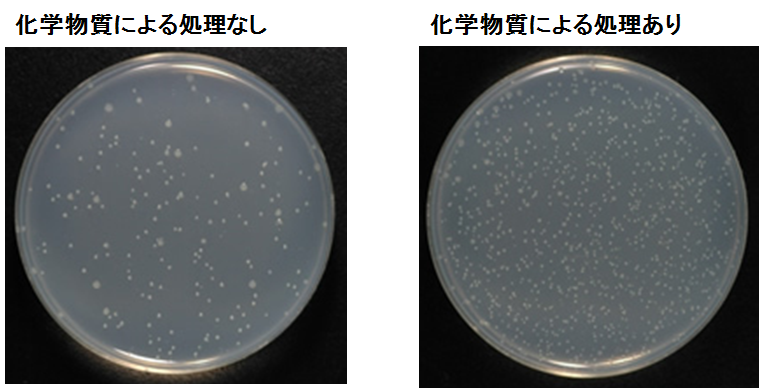

遺伝毒性:化学物質により遺伝子に傷が付く
1.はじめに
労働者は、労働現場で取り扱っている化学物質にばく露されることがあるため、それによる健康障害が起きないように許容濃度が設定されています。近年は、労働現場で健康障害がでるような事例は少なくなっていますが、大阪の印刷工場で印刷機の洗浄・払拭事務に従事していた労働者で胆管がんが多発したことが報道されたことは記憶に新しいと思います。労働現場では多様な化学物質が使用されており、これらを適切に管理し、労働者の健康を維持するためには、その毒性を知る必要があります。
化学物質が生体又はその構成要素(臓器、組織、細胞など)に対して示す悪影響を毒性といいますが、その中で、遺伝情報を担う物質であるDNAに対する悪影響を遺伝毒性と言います。私は現在、労働環境で使用される粒子状物質や有機溶剤の遺伝毒性について研究しています。ここでは、遺伝毒性とは何かということと私が行っている粒子状物質の遺伝毒性評価に関する研究内容の一部について御紹介します。
2.遺伝毒性とは
遺伝毒性とは「遺伝情報を担うDNA(遺伝子や染色体)に変化を与え、個体に悪影響をもたらす性質」のことを言います。
DNAは、アデニン(A)、グアニン(G)、シトシン(C)、チミン(T)の4つの塩基を含む2本の鎖が対合した2重らせん構造をしており、生物の構造と機能を維持するために必要な情報が書かれています。細胞が2つに分裂する時には、DNAも2倍になる必要があるため、細胞内でDNAの複製が行われます。この時、AとT及びCとGが必ず対になることにより、DNAに書かれている情報が正確に保存されてDNAの複製が行われます(図1A)。しかしながら、化学物質やその代謝物などがDNAの塩基と結合すると、DNA複製時に誤って他の塩基と対を形成してしまう確率が高くなることがあります。その結果、DNAの塩基配列に変化が起きてしまい、そこに書かれている情報が正常なものとは異なるものになってしまいます(図1B)。また、化学物質によっては、DNA鎖が切断されて、欠失などの大きな変化をDNAに与えることもあります。さらに、DNAに一度起きてしまった変化は、もとに戻ることはなく蓄積していきます。このような突然変異が、細胞増殖や遺伝子の安定性に関わる機能を果たす遺伝子(例えば遺伝子の守護神と呼ばれるがん抑制遺伝子であるp53遺伝子(参考資料1、2))で起きると、細胞のがん化が促進されます。このように、DNAに傷が付き、変異が起きることと発がんは密接な関係にあり、ある化学物質に遺伝毒性があるかどうかを調べることは、その化学物質に発がん性があるかどうかを調べる際に重要となります。
3.遺伝毒性を評価する
遺伝毒性は、遺伝子に生じる突然変異を調べたり、細胞の染色体の構造の異常や染色体の数の異常を調べたりすることで検出ができます。遺伝毒性を評価する方法は、微生物や培養細胞を用いる方法から、マウスやラットなどの実験動物を用いる方法まで様々あります。微生物を用いる方法で有名なのがエームス試験 (OECDテストガイドライン TG471) であり、労働安全衛生法では新規化学物質の製造又は輸入に際し、実施することが定められています。
エームス試験は、必須アミノ酸のヒスチジンがないと生育できない変異を持つ複数のサルモネラ菌株を用います。変異株はいずれもヒスチジンを生合成できないため、生育にヒスチジンが必要です。しかし化学物質による突然変異でヒスチジンを合成できるようになると、ヒスチジンを含まない培地上でも生育できるようになり、コロニーと呼ばれる菌の塊を形成します(図2)。このコロニーを数えることで化学物質の変異原性の強さを調べます。この試験により強い変異原性が認められた化学物質については、取扱いの際は、健康障害を防止するための措置を講ずる必要があります。
通常、化学物質の遺伝毒性の見落としを防ぐために、エームス試験と併用して、培養細胞や動物を使用した遺伝毒性の評価も行います。培養細胞や動物では、染色体異常誘発性を検出するための染色体異常試験や小核試験、及び変異原性を調べるための遺伝子突然変異試験などが行われます(OECDテストガイドライン TG471-488)。これらの試験結果を総合的に評価し、遺伝毒性の有無を判断することになります。
4.粒子状物質の遺伝毒性の評価方法とその問題点
労働現場では、有機溶剤や粒子物質など様々な種類の化学物質が扱われます。最近では、ナノ粒子(たて・横・高さのうち少なくとも一つが1~100 ナノメートルのサイズ範囲である粒子のこと)をはじめとする粒子状物質の毒性が懸念されています。先述したように、労働安全衛生法ではエームス試験によって化学物質の変異原性を調べることが定められていますが、エームス試験で使用されるサルモネラ菌をはじめとする細菌には細胞壁があります。水溶性の化学物質であれば細胞壁を通過し、細胞内にあるDNAと直接反応するチャンスが生まれます。しかし、不溶性の粒子状物質はかなり小さいサイズの粒子でない限り細胞壁を通過できず、細胞内に入らないため、DNAと反応するチャンスはありません。そのため、遺伝毒性が有るのに、無いと評価される「偽陰性」を示すことがあるといわれています。
培養細胞での遺伝毒性実験においても、(1) 粒子が細胞内に取り込まれない、(2) 実験条件により遺伝毒性の結果が変わってしまうなどの課題が残されています。 (1) については、マクロファージなどの積極的に異物を取り込むことができる細胞を用いることが解決策の一つとして考えられます。実際に、マクロファージを使用した実験では、粒子が取り込まれて毒性が出ることがわかりました。(2) については、細胞培養培地に含まれる成分である血清の有無で遺伝毒性の結果が変わることがわかり、さらに細胞内への粒子の取り込み量を調べたところ、血清の有無で粒子の取り込み量に変化が見られました。
また、ナノ粒子は、実験条件(粒子を懸濁する溶液に含まれる成分、血清の有無、分散方法など)による粒子の分散状態の違いが遺伝毒性の評価結果に影響することも知られているため、遺伝毒性を調べる上で粒子の分散状態を把握することが重要になります。このように、粒子状物質の遺伝毒性評価は、実験条件を十分に検討した上で行う必要があります。他にも、除去しきれずに残留した粒子が解析に影響するなどの問題点もあるため、今後、このような問題点を改善し遺伝毒性をできる限り正確に評価できるように研究を進めていく必要があります。
5.おわりに
遺伝毒性が毒性学の分野で重要な位置を占める理由の一つは、遺伝毒性を示す発がん物質の発がん作用には、閾値がないとされるためです。つまり、遺伝毒性を示す化学物質は、どんなに少量でも発がんの可能性があると考えられています。そのため、許容濃度はこの濃度以下なら全くがんが発生しないという値ではなく、実質安全量(注記)が用いられます(図2)。また、先でも述べたように、労働安全衛生法では、強い変異原性が認められる化学物質については、その取扱いに特別な注意を払うよう定められています。このように労働現場で使用される化学物質に遺伝毒性が認められる場合、リスクを評価する際の許容濃度の設定の方法や労働現場での取り扱いが異なってくるため、遺伝毒性の有無を調べることは、労働者の健康障害予防のために重要となります。
私は、現在、ナノ粒子をはじめとする粒子状物質や有機溶剤の毒性研究において、毒性の指標の一つとして遺伝毒性の解析を行っています。これらの研究成果を通じて、労働現場での化学物質の適切な管理及び労働者の健康保持に貢献していきたいと思います。
(健康障害予防研究グループ 任期付研究員 佐治哲矢)
注記
実質安全量: 遺伝毒性発がん物質は閾値が存在しないという立場から出発した評価法。10 万分の1 あるいは100 万分の1 という低い確率でがんを増加させる値で、交通事故など通常の生活で遭遇する稀なリスクと同程度と解釈される。
(参考資料)
- p53: ゲノムの守護神(実験医学 1998年10月号 Vol.16 No.15):
- p53: guardian of the genome and policeman of the oncogenes. (Cell Cycle. 2007, Vol.6, p1006-10)
- OECDテストガイドライン: http://www.nihs.go.jp/hse/chem-info/oecdindex.html